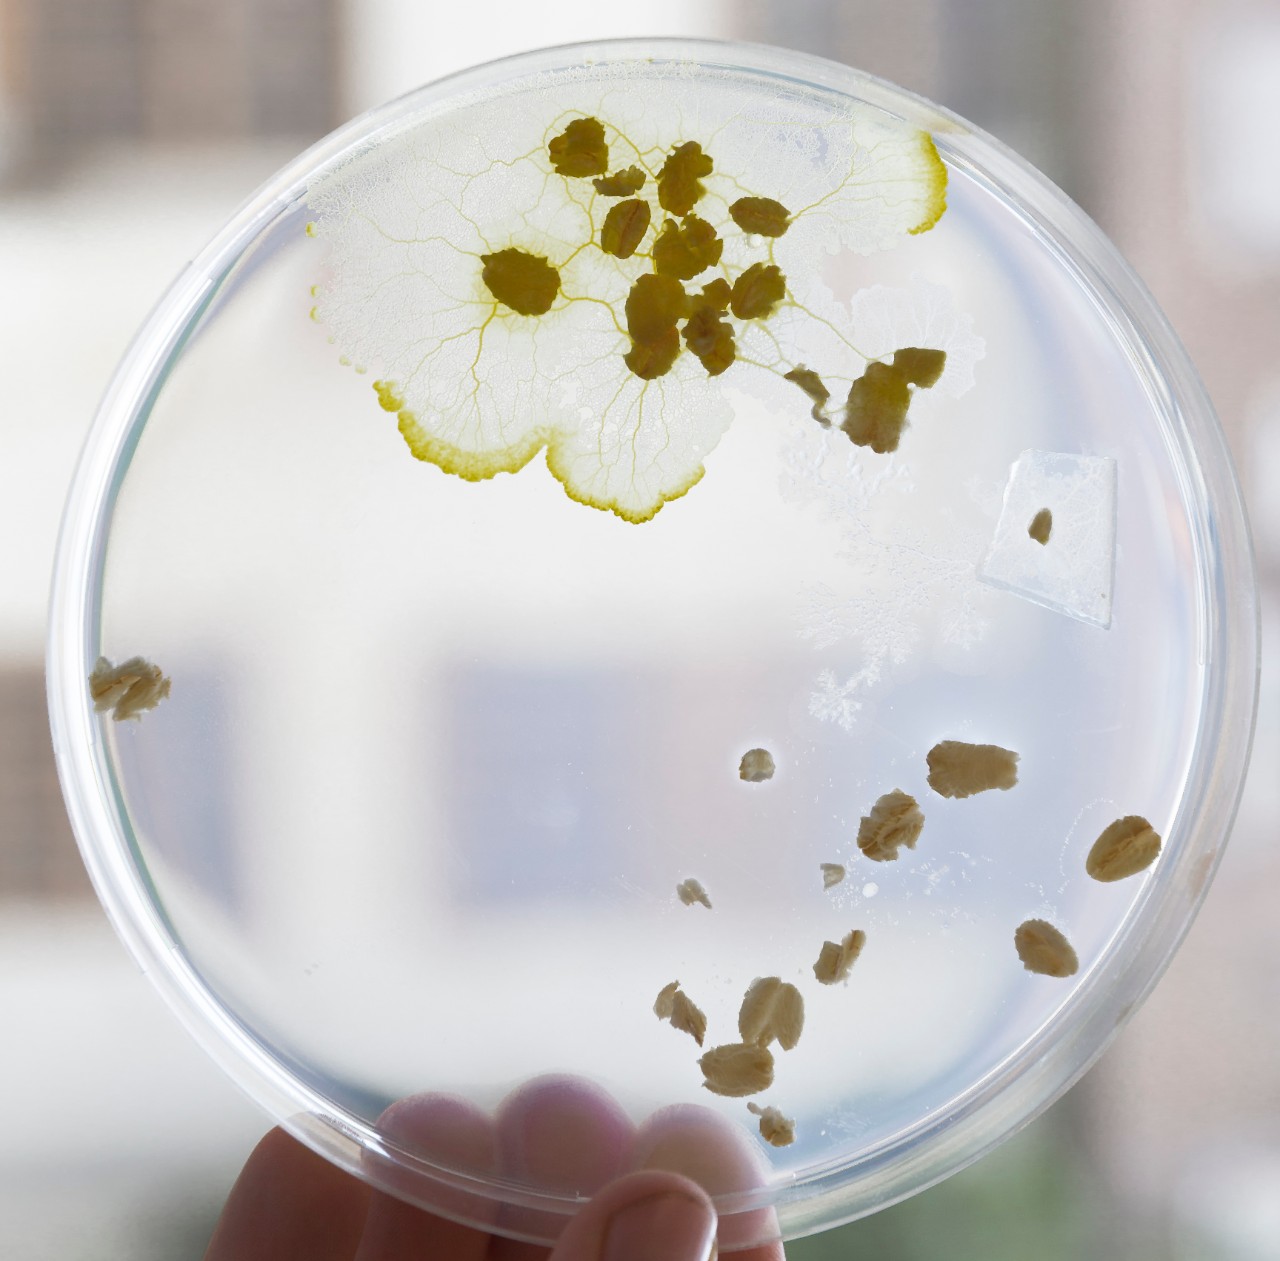
A slime mould

Insects bring new ideas to urban design

Entomologist Dr Tanya Latty works with ants, bees, soldier fly larvae, even slime moulds - and leaf insects, as pictured here.
Attention: Elon Musk. Re: Driverless cars. Are there any meat ants working at Tesla? If not, talk to Dr Tanya Latty, a Research and Teaching Fellow in Entomology at the University of Sydney. Among other projects, her team is looking at how meat ants organise themselves, so this can be applied to algorithms for driverless car systems.
“Driverless cars communicate with one another to minimise traffic times across the network,” says Latty. “But what happens if one car puts in bad information? Without proper controls that gets propagated through the whole network and you can have all these unforeseen patterns.”
Meanwhile, ants have been running decentralised communication systems forever. The meat ant, in particular, has become adept at preventing misinformation. Many ants leave a pheromone chemical trail that other ants follow to a food source or back to the nest. This is why ants often travel in strict lines.
“But the meat ant goes one better,” says Latty. “If we move the pheromone trail so that it’s going in the wrong direction, an ant will default to its memory and go the way that it’s been before.” The mechanics and implications of this are still being investigated.
At dinner parties, Latty is frequently misunderstood. Hearing she’s an entomologist, fellow diners are liable to request that she helps out with their cockroach infestation. “Then there’s a long explanation about, ‘Well, I don’t technically work in pest management’,” Latty says. Then she corrects herself. “In a way, I do.”
In Latty’s lab, researchers work with ants, bees, soldier fly larvae and even slime moulds. Often – as with the meat ants and the driverless cars – swarm intelligence is observed to create bio-inspired algorithms that can be applied to all kinds of human networks, from computers to roads. Sometimes, though, these invertebrates rebel and make a run for it.

Insects make up over 70 percent of all animal life - but worryingly, the mass of insects is declining by 2.5 percent a year.
“Gosh, we have breakouts all the time,” says Latty. “The lab is basically one giant breakout. We have maggots everywhere right now, crawling randomly around.”
Growing up near Toronto, in Canada, the young Latty would use her mother’s nail polish to mark the slaters crawling around her childhood home, so she could tell which lived where.
“I’m not sure I knew that I wanted to be an entomologist per se, but I wanted to do something with living things,” she says. “My parents both have science backgrounds, so they were just happy I was doing something sciencey, even though they weren’t particularly happy with the things that were coming home.”
After school, she undertook an undergraduate degree in environmental science and biology, and was particularly drawn to an entomology class. Today, when she isn’t teaching or writing papers and grants, she’s busy in the lab or out in the field.
“Last week, I was in Tasmania with one of my students where we set up a project looking at pollination in blueberries, apples and market gardens,” she says. “This morning I spent a lot of time staring at soldier fly larvae to try to work out what they’re doing.”
A day at work for Latty isn’t all about insects. She also admits to an odd affection for the mysterious slime moulds of the world. Slime mould might look like a fungus but it’s actually part of the Protista kingdom, considered the least understood of the five kingdoms of life (the others being bacteria, fungi, plants and animals).
This very elemental creature is made up of just one large cell containing many nuclei, yet it exhibits behaviours that look very much like intelligence. Using a food lure, slime mould can solve a maze, and where there are two ways out, the mould will find the shortest route – all without having anything even vaguely brain-like. But it’s the way slime moulds move that has attracted Latty’s attention.
Slime mould, part of the Protista kingdom, is still one of the most mysterious forms of life.
Slime mould movement has been described as ‘streaming’, which it does by pulsing its internal fluid to the front of the cell. How this happens is still not fully understood since there is no apparatus controlling the pulsing, making it a form of forward motion that is uniquely decentralised.
“If it’s in contact with something it likes, such as a food source, the bit nearest the food will pulse faster and send more biomass flowing in that direction,” Latty explains.
These observations give insights into the roughly 99 percent of life on Earth which is functionally brainless but sometimes looks like it’s making decisions. This includes things like the bacteria that make us sick, and macrophages that search and destroy pathogens in our bodies. It’s becoming increasingly clear that the brainless majority is not nearly as ‘unintelligent’ as we thought.
On a completely different tack, Latty’s work with soldier fly larvae is focused on making better use of wasted food. The larvae can turn food waste into high-quality protein, which can then be processed into human food, animal feed, or even biodiesel fuel. “You could have fly breeding operations in city buildings, processing some of our waste,” she hypothesises. “It’s also more ethical than eating livestock because soldier fly maggots love being on top of one another, so you can keep them in super-high densities.”
Our planet is an insect planet. A third of our food is insect-pollinated. Cockroaches and ants recycle our rubbish and keep us from drowning in our own waste. Insects are also an essential foundation stone of the entire food chain.
Yet now we are confronted with the idea that insect populations are crashing, as the mass of insects internationally declines by 2.5 percent a year. The effect is perhaps most broadly felt in Australia as people notice that Christmas beetles and bogong moths are missing their regular appearances, and car windscreens are virtually insect-free after country drives.
If we are noting these absences, the many birds and animals that eat insects are noticing as well.
It also pains Latty that insects – which make up more than 70 percent of all animal life – have such a low approval rating, and are rarely on the receiving end of petitions from armchair conservationists.
“We’ve identified, best estimate, 20 percent of insect species, so every time we lose a species, we’re losing all the information and possibilities that species contained,” she says. “It’s like burning a library without having an index of what you’ve lost.”
Written by Jenny Valentish
Photography by Louise Cooper